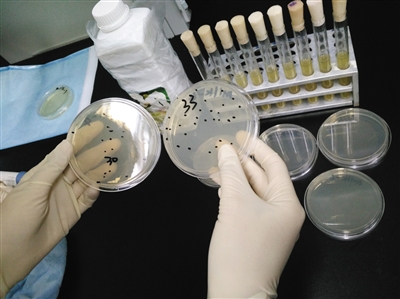

首页>寻医·问药>食话食说食话食说
现挤牛奶违规网售:菌落总数最高超标1450倍
网上不少卖家直接售卖现挤生鲜奶,宣称纯天然。新京报记者 王远征 摄
实验室人员对生鲜奶样品进行取样测试。实验室人员对生鲜奶样品进行取样测试。
有一份生鲜奶样品的菌落总数严重超标。有一份生鲜奶样品的菌落总数严重超标。
“百分百纯牛奶,无任何添加,不含一滴水,自家牧场直销……”这是网上卖家“中晴老牧民”打出的宣传语。其销售的“纯牛奶”售价为1公斤17.98元,累计成交记录已有230多笔,买家也好评不断。
一些消费者觉得来自牧场的现挤生鲜奶比超市卖的纯牛奶更新鲜、更原生态。在电商平台上,类似“中晴老牧民”这样的生鲜奶商家并不少,零售价普遍 在每公斤16-20元,与目前每公斤普遍不超过4元的生奶收购价形成鲜明对比。与此同时,许多商家还在线下做起了生鲜奶批发生意,每单成交量普遍在50公 斤以上。
这些商家中,有的自称来自与大乳企合作的牧场,有的是饲养牛羊的散户,有的则是专门收购生鲜奶赚取差价的奶贩子。
我国《生鲜乳生产收购管理办法》、《乳品质量安全监督管理条例》规定,禁止其他单位或个人收购生鲜乳,禁止收购“经检测不符合健康标准或未经检 疫合格的奶畜产的生鲜乳”。但在“高价”的诱惑下,存在安全风险,有的甚至都没检测的生鲜奶正以网上零售、线下批发这两条“地下”交易路线涌向消费者的餐 桌。
尽管商家们对生鲜奶使用冰块、冰袋等简单的冷链配送,还建议煮沸,但其安全性远不是这么简单就能解决的。国家食药监总局今年7月10日发表《食 品安全风险解析》,专门组织专家对生鲜奶的营养价值及安全性进行全面解析,指出生鲜奶在营养上并无特别之处,反而存在感染布鲁氏菌病等健康风险。
编辑:赵彦
关键词:现挤牛奶违规网售 菌落总数最高超标1450倍

中国制造助力孟加拉国首条河底隧道项目
澳大利亚猪肉产业协会官员看好进博会机遇
联合国官员说叙利亚约1170万人需要人道主义援助
伊朗外长扎里夫宣布辞职
中国南极中山站迎来建站30周年
联合国特使赴也门斡旋荷台达撤军事宜
以色列前能源部长因从事间谍活动被判11年监禁
故宫博物院建院94年来首开夜场举办“灯会”
法蒂玛·马合木提
王召明
王霞
辜胜阻
聂震宁
钱学明
孟青录
郭晋云
许进
李健
覺醒法師
吕凤鼎
贺铿
金曼
黄维义
关牧村
陈华
陈景秋
秦百兰
张自立
郭松海
李兰
房兴耀
池慧
柳斌杰
曹义孙
毛新宇
詹国枢
朱永新
张晓梅
焦加良
张连起
龙墨
王名
何水法
李延生
巩汉林
李胜素
施杰
王亚非
艾克拜尔·米吉提
姚爱兴
贾宝兰
谢卫
汤素兰
黄信阳
张其成
潘鲁生
冯丹藜
艾克拜尔·米吉提
袁熙坤
毛新宇
学诚法师
宗立成
梁凤仪
施 杰
张晓梅


